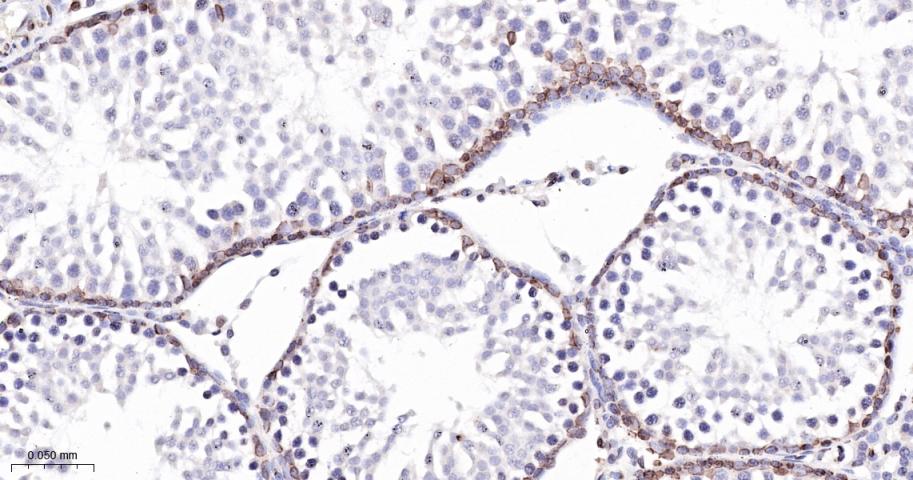
SUN2重组兔单抗
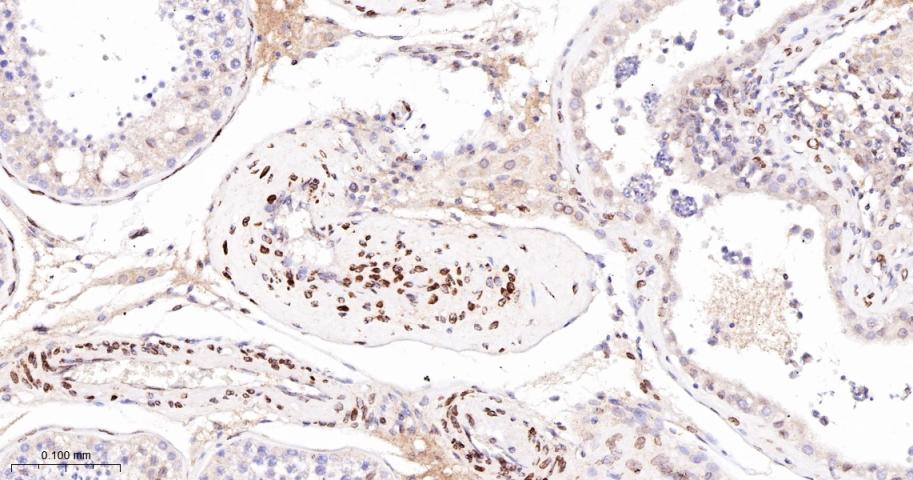
SUN2重组兔单抗
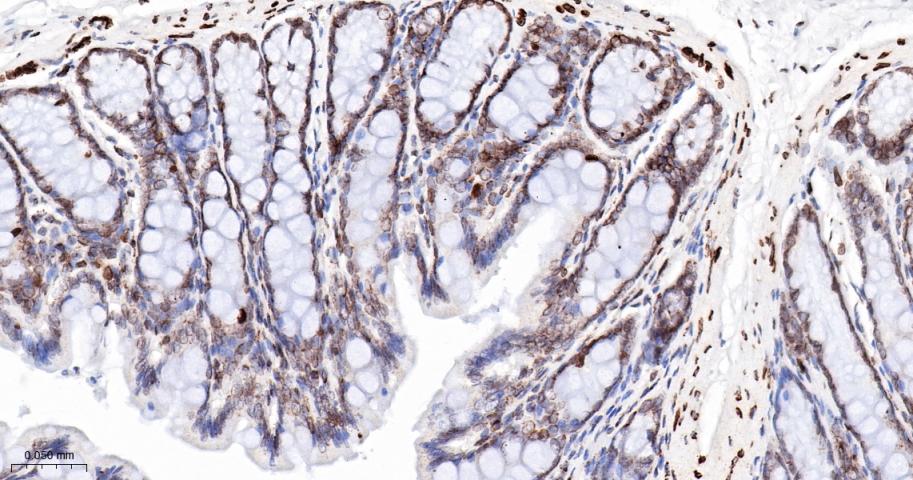
SUN2重组兔单抗
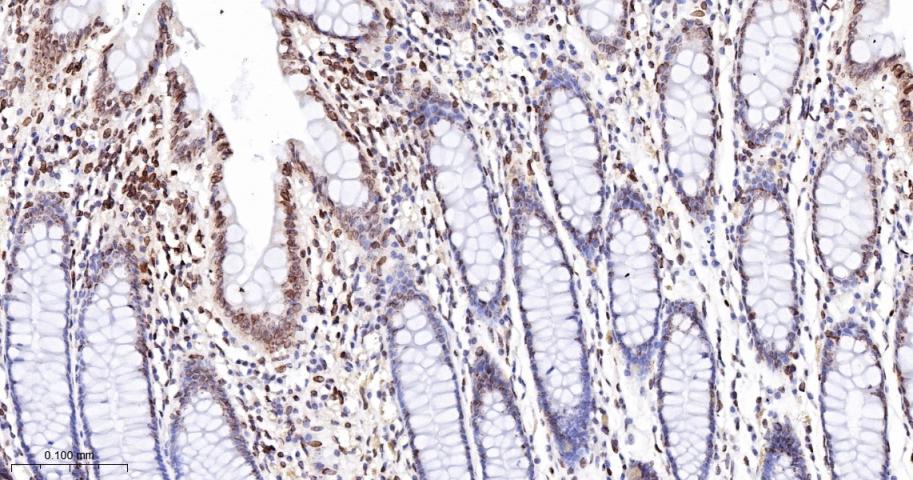
SUN2重组兔单抗

SUN2重组兔单抗
Rrmab?兔单抗

货号:bsm-54421R
产品详情
相关标记
相关产品
相关文献
常见问题
概述
产品编号
bsm-54421R
产品类型
重组兔单抗
英文名称
SUN2 Recombinant Rabbit mAb
中文名称
SUN2重组兔单抗
英文别名
UNC84B; rab5IP; B230369L08Rik; C030011B15; RGD1563141; SUN2_HUMAN; SUN2; Protein unc-84 homolog B; Rab5-interacting protein (Rab5IP); Sad1/unc-84 protein-like 2; FRIGG; KIAA0668; SUN2_MOUSE;
抗体来源
Rabbit
免疫原
Recombinant protein within human SUN2 aa 500-700.
亚型
IgG
性状
Liquid
纯化方法
affinity purified by Protein A
克隆类型
Recombinant
克隆号
11A8
理论分子量
80 kDa
浓度
1mg/ml
储存液
0.01M TBS (pH7.4) with 1% BSA, 0.02% Proclin300 and 50% Glycerol.
研究领域
Gene ID
保存条件
Shipped at 4℃. Store at -20℃ for one year. Avoid repeated freeze/thaw cycles.
注意事项
This product as supplied is intended for research use only, not for use in human, therapeutic or diagnostic applications.
数据库链接
背景资料
SUN1 (MIM 607723) and SUN2 are inner nuclear membrane (INM) proteins that play a major role in nuclear-cytoplasmic connection by formation of a 'bridge' across the nuclear envelope, known as the LINC complex, via interaction with the conserved luminal KASH domain of nesprins (e.g., SYNE1; MIM 608441) located in the outer nuclear membrane (ONM). The LINC complex provides a direct connection between the nuclear lamina and the cytoskeleton, which contributes to nuclear positioning and cellular rigidity (summary by Haque et al., 2010 [PubMed 19933576]).[supplied by OMIM, Nov 2010]

产品应用
| 应用 | 已检合格种属 | 预测种属 | 推荐稀释比例 |
|---|---|---|---|
| WB | Human, Mouse | Rat | 1:500-2000 |
| IHC-P | Human, Mouse, Rat | 1:50-200 | |
| IHC-F | Human, Mouse, Rat | 1:50-200 | |
| IF | Human, Mouse, Rat | 1:50-200 | |
| ICC/IF | Human, Mouse, Rat | 1:50-200 |
交叉反应
交叉反应: Human, Mouse, Rat
相关产品
暂无相关产品
靶标
基因名
SUN2
蛋白名
SUN domain-containing protein 2
组织特异性
Widely expressed. Highly expressed in heart, lung and muscle. Weakly expressed in fetal heart. Slightly overexpressed in some heart tissues form patients with congenital heart defects.
翻译后修饰
The disulfid bond with SYNE2 is required for stability of the SUN2:SYNE2/KASH2 LINC complex under tensile forces though not required for the interaction. The disulfid bond is proposed to be conserved in LINC complexes involved in force transmission.
功能
As a component of the LINC (LInker of Nucleoskeleton and Cytoskeleton) complex, involved in the connection between the nuclear lamina and the cytoskeleton. The nucleocytoplasmic interactions established by the LINC complex play an important role in the transmission of mechanical forces across the nuclear envelope and in nuclear movement and positioning. Specifically, SYNE2 and SUN2 assemble in arrays of transmembrane actin-associated nuclear (TAN) lines which are bound to F-actin cables and couple the nucleus to retrograde actin flow during actin-dependent nuclear movement. Required for interkinetic nuclear migration (INM) and essential for nucleokinesis and centrosome-nucleus coupling during radial neuronal migration in the cerebral cortex and during glial migration. Required for nuclear migration in retinal photoreceptor progenitors implicating association with cytoplasmic dynein-dynactin and kinesin motor complexes, and probably B-type lamins; SUN1 and SUN2 seem to act redundantly. The SUN1/2:KASH5 LINC complex couples telomeres to microtubules during meiosis; SUN1 and SUN2 seem to act at least partial redundantly. Anchors chromosome movement in the prophase of meiosis and is involved in selective gene expression of coding and non-coding RNAs needed for gametogenesis. Required for telomere attachment to nuclear envelope and gametogenesis. May also function on endocytic vesicles as a receptor for RAB5-GDP and participate in the activation of RAB5.
标记抗体
暂无标记数据
同靶标产品
暂无同靶标产品
相关文献
提示: 发表研究结果有使用 bsm-54421R 时请让我们知道,以便我们可以引用参考文章。作为回馈,资料提供者将获得我们送上的小礼品。
暂无相关文献
常见问题
暂无常见问题